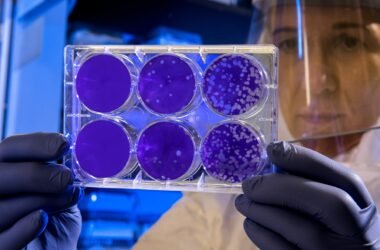

Сотрудники полиции во Вроцлаве задержали 38-летнюю женщину, которая в ночь перед Днём Независимости Польши заложила взрывное устройство в центре Варшавы.
В ночь с 10 на 11 ноября в столице варшавской полицией было обнаружено самодельное взрывное устройство, содержащее газовые баллоны, стекло и гвозди, представляющее серьёзную угрозу для здоровья и жизни людей. Службы безопасности незамедлительно начали поиск лица, ответственного за установку устройства.
Благодаря видеозаписям с камер наблюдения полиция сфокусировала своё внимание на женщине, запечатленной камерами на месте установки взрывного устройства. После его установки она последовала до Центрального железнодорожного вокзала и уехала поездом в направлении Вроцлава, а затем вернулась в свой дом в гмине Стшелин.
Сотрудники полиции и отдела по борьбе с терроризмом задержали 38-летнюю женщину по месту её проживания. В ходе обыска выяснилось, что женщина интересуется ситуацией на Ближнем Востоке. Сотрудниками полиции были обнаружены предметы и гаджеты, связанные с различными запрещёнными террористическими организациями, а также предметы, которые могли быть использованы для изготовления другого взрывного устройства.
Женщина была доставлена в Варшаву, где ей были предъявлены обвинения. Женщине грозит до 10 лет тюремного заключения.